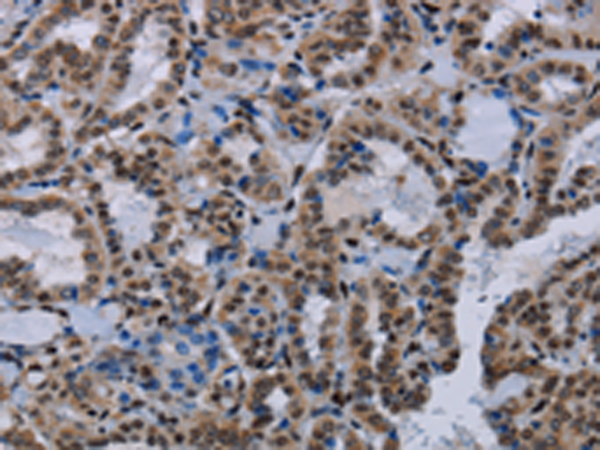
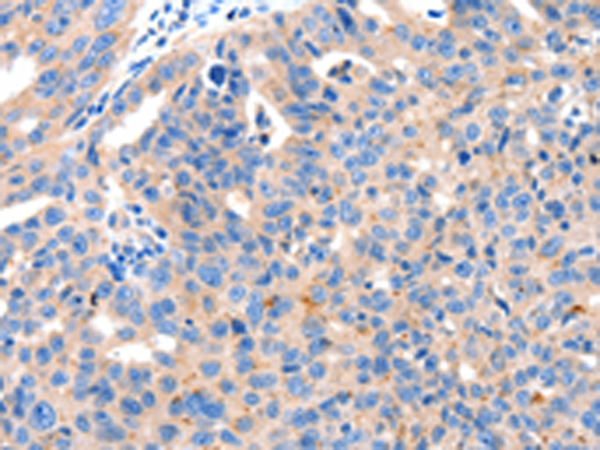

-
分类: 科研抗体货号: P10953别名: HMG2应用: WB反应种属: Human, Mouse, Rat
-
分类: 科研抗体货号: P10952别名: HMG1; HMG3; SBP-1应用: WB,IHC反应种属: Human, Mouse, Rat
-
分类: 科研抗体货号: P10970别名: p33; p47; p33ING1; p24ING1c; p33ING1b; p47ING1a应用: WB反应种属: Human, Mouse
-
分类: 科研抗体货号: P10947别名: HD2, RPD3, YAF1应用: IHC反应种属: Human, Mouse
-
分类: 科研抗体货号: P10984别名: EA1, MK1, AEMK, HBK1, HUK1, MBK1, RBK1, KV1.1应用: WB,IHC反应种属: Human, Mouse, Rat
-
分类: 科研抗体货号: P10969别名: IL3R; CD123; IL3RX; IL3RY; IL3RAY; hIL-3Ra应用: IHC反应种属: Human
-
分类: 科研抗体货号: P10946别名: HD1, RPD3, GON-10, RPD3L1应用: WB,IHC反应种属: Human, Mouse, Rat
-
分类: 科研抗体货号: P10983别名: hK2, hGK-1, KLK2A2应用: IHC反应种属: Human
-
分类: 科研抗体货号: P10967别名: CD215应用: WB,IHC反应种属: Human, Mouse, Rat
-
分类: 科研抗体货号: P10943别名: SSS2应用: IHC反应种属: Human, Mouse, Rat

鄂公网安备42018502007531号
鄂公网安备42018502007531号

